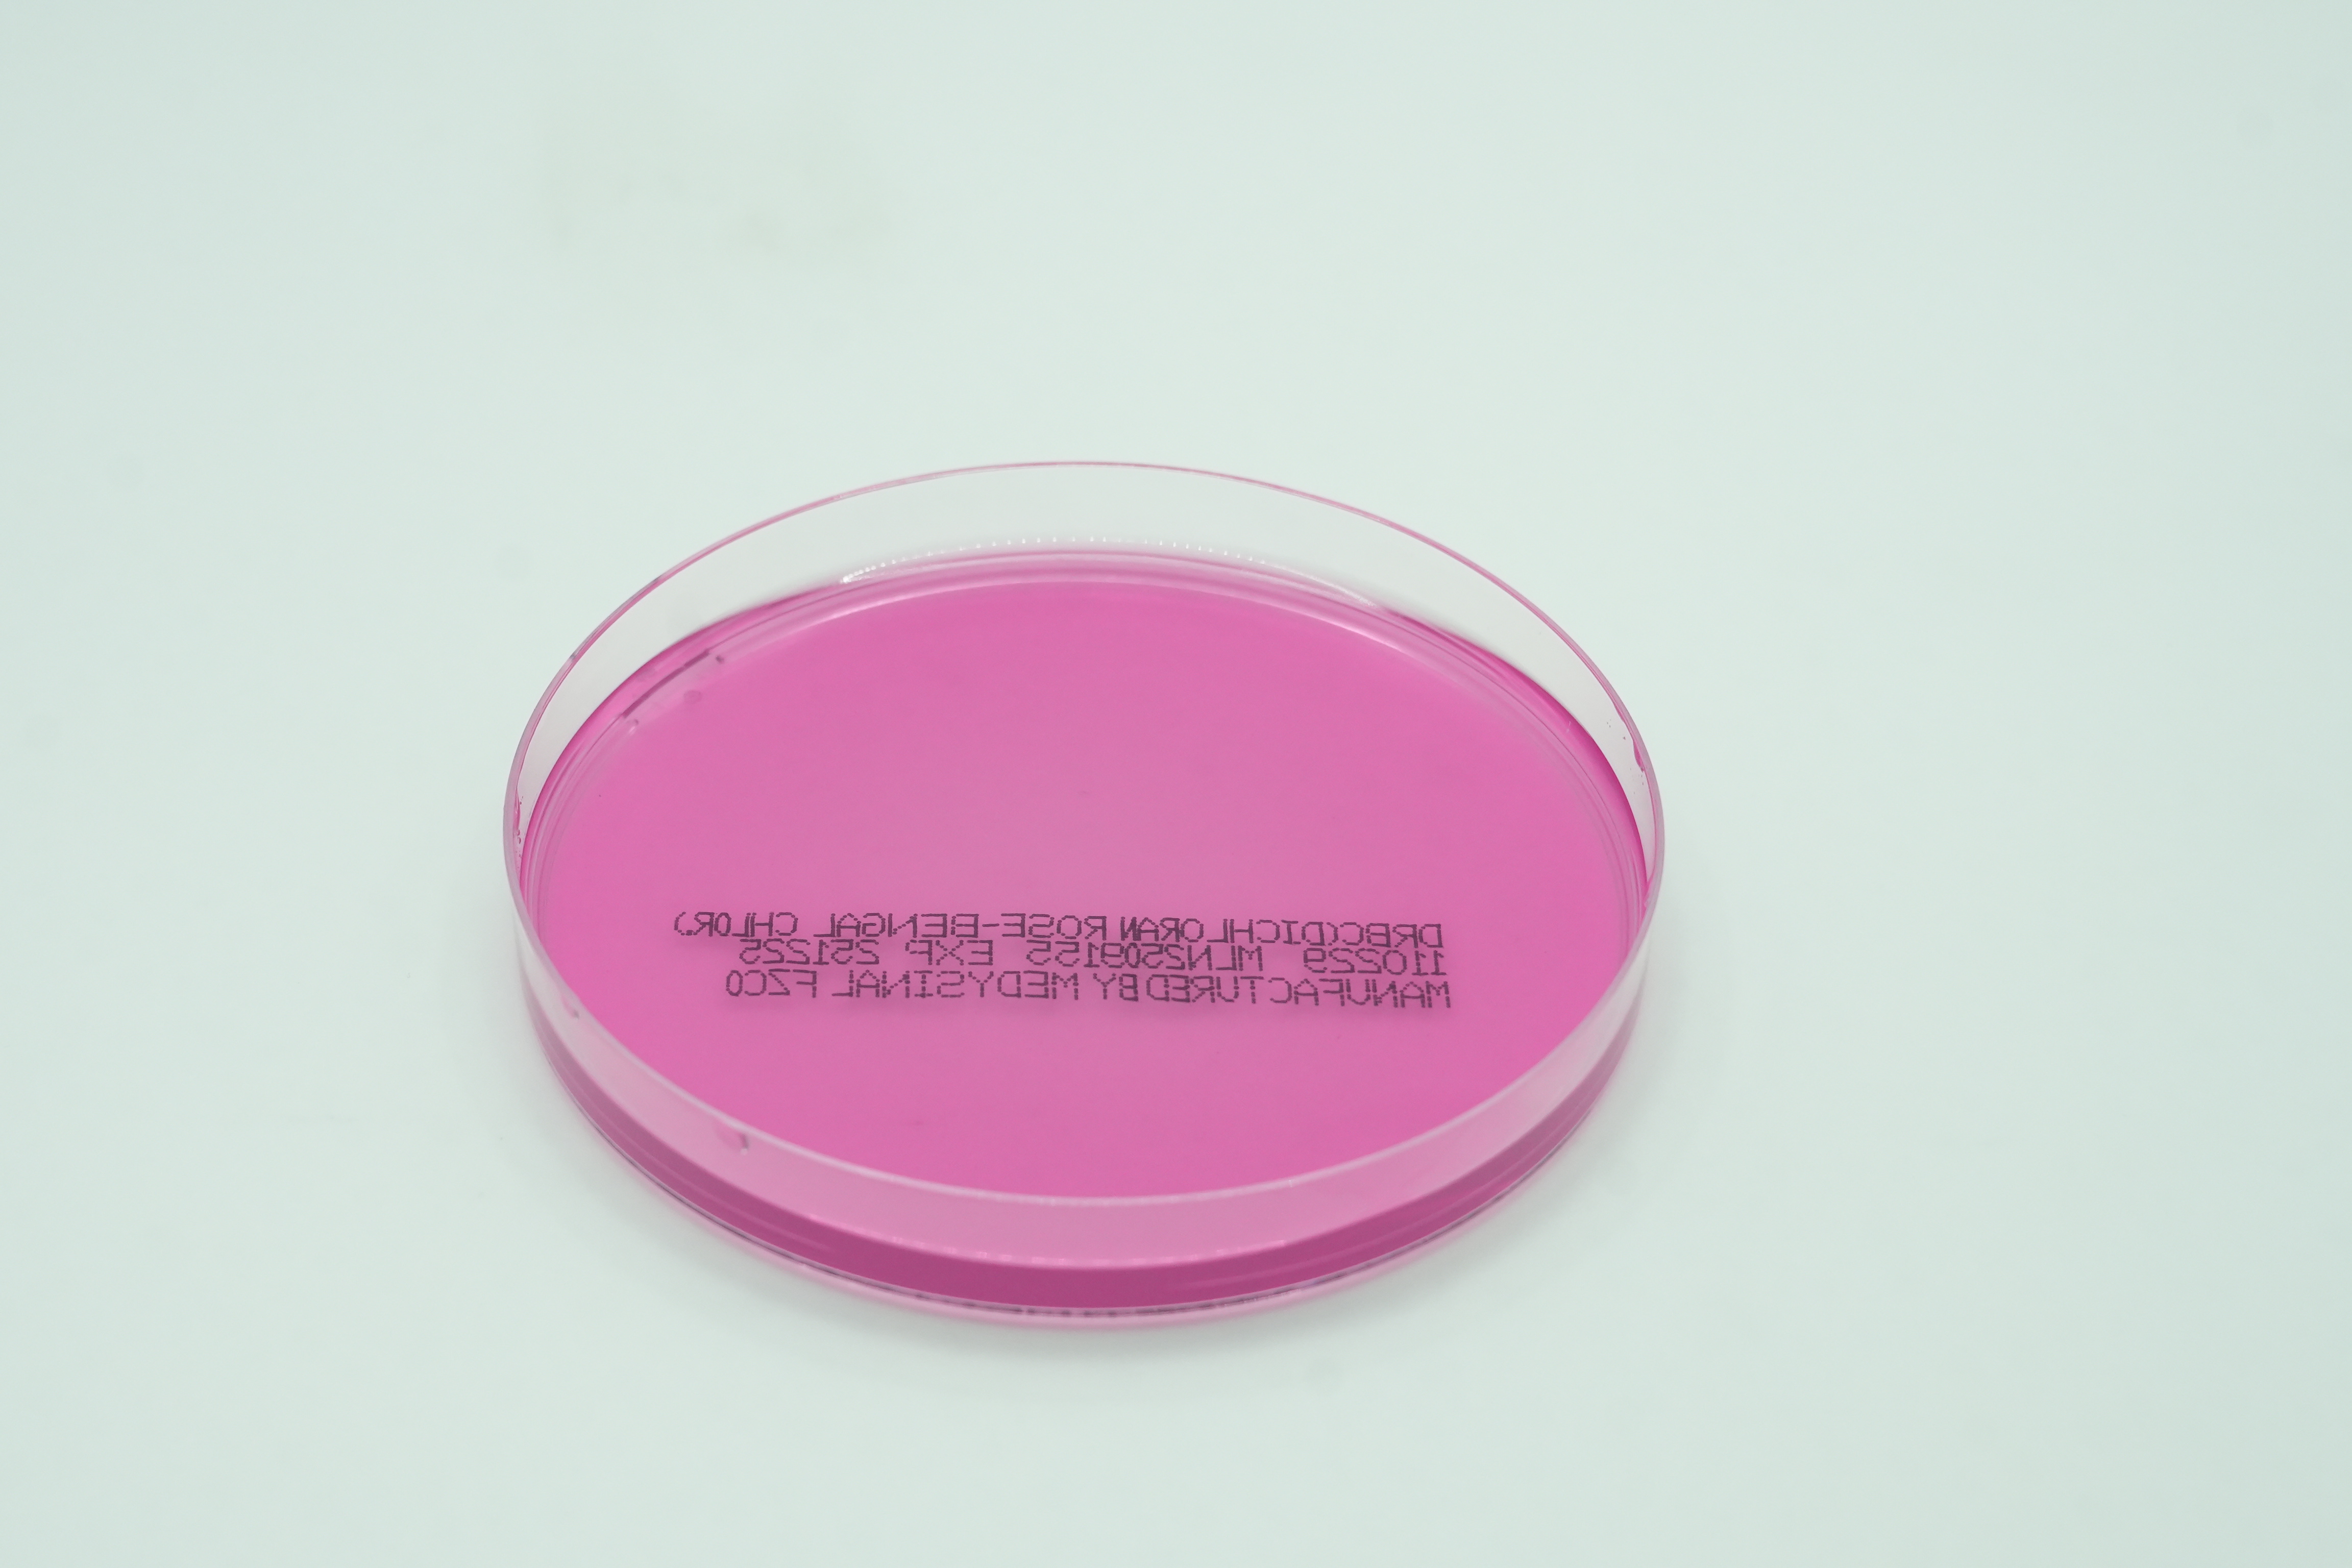
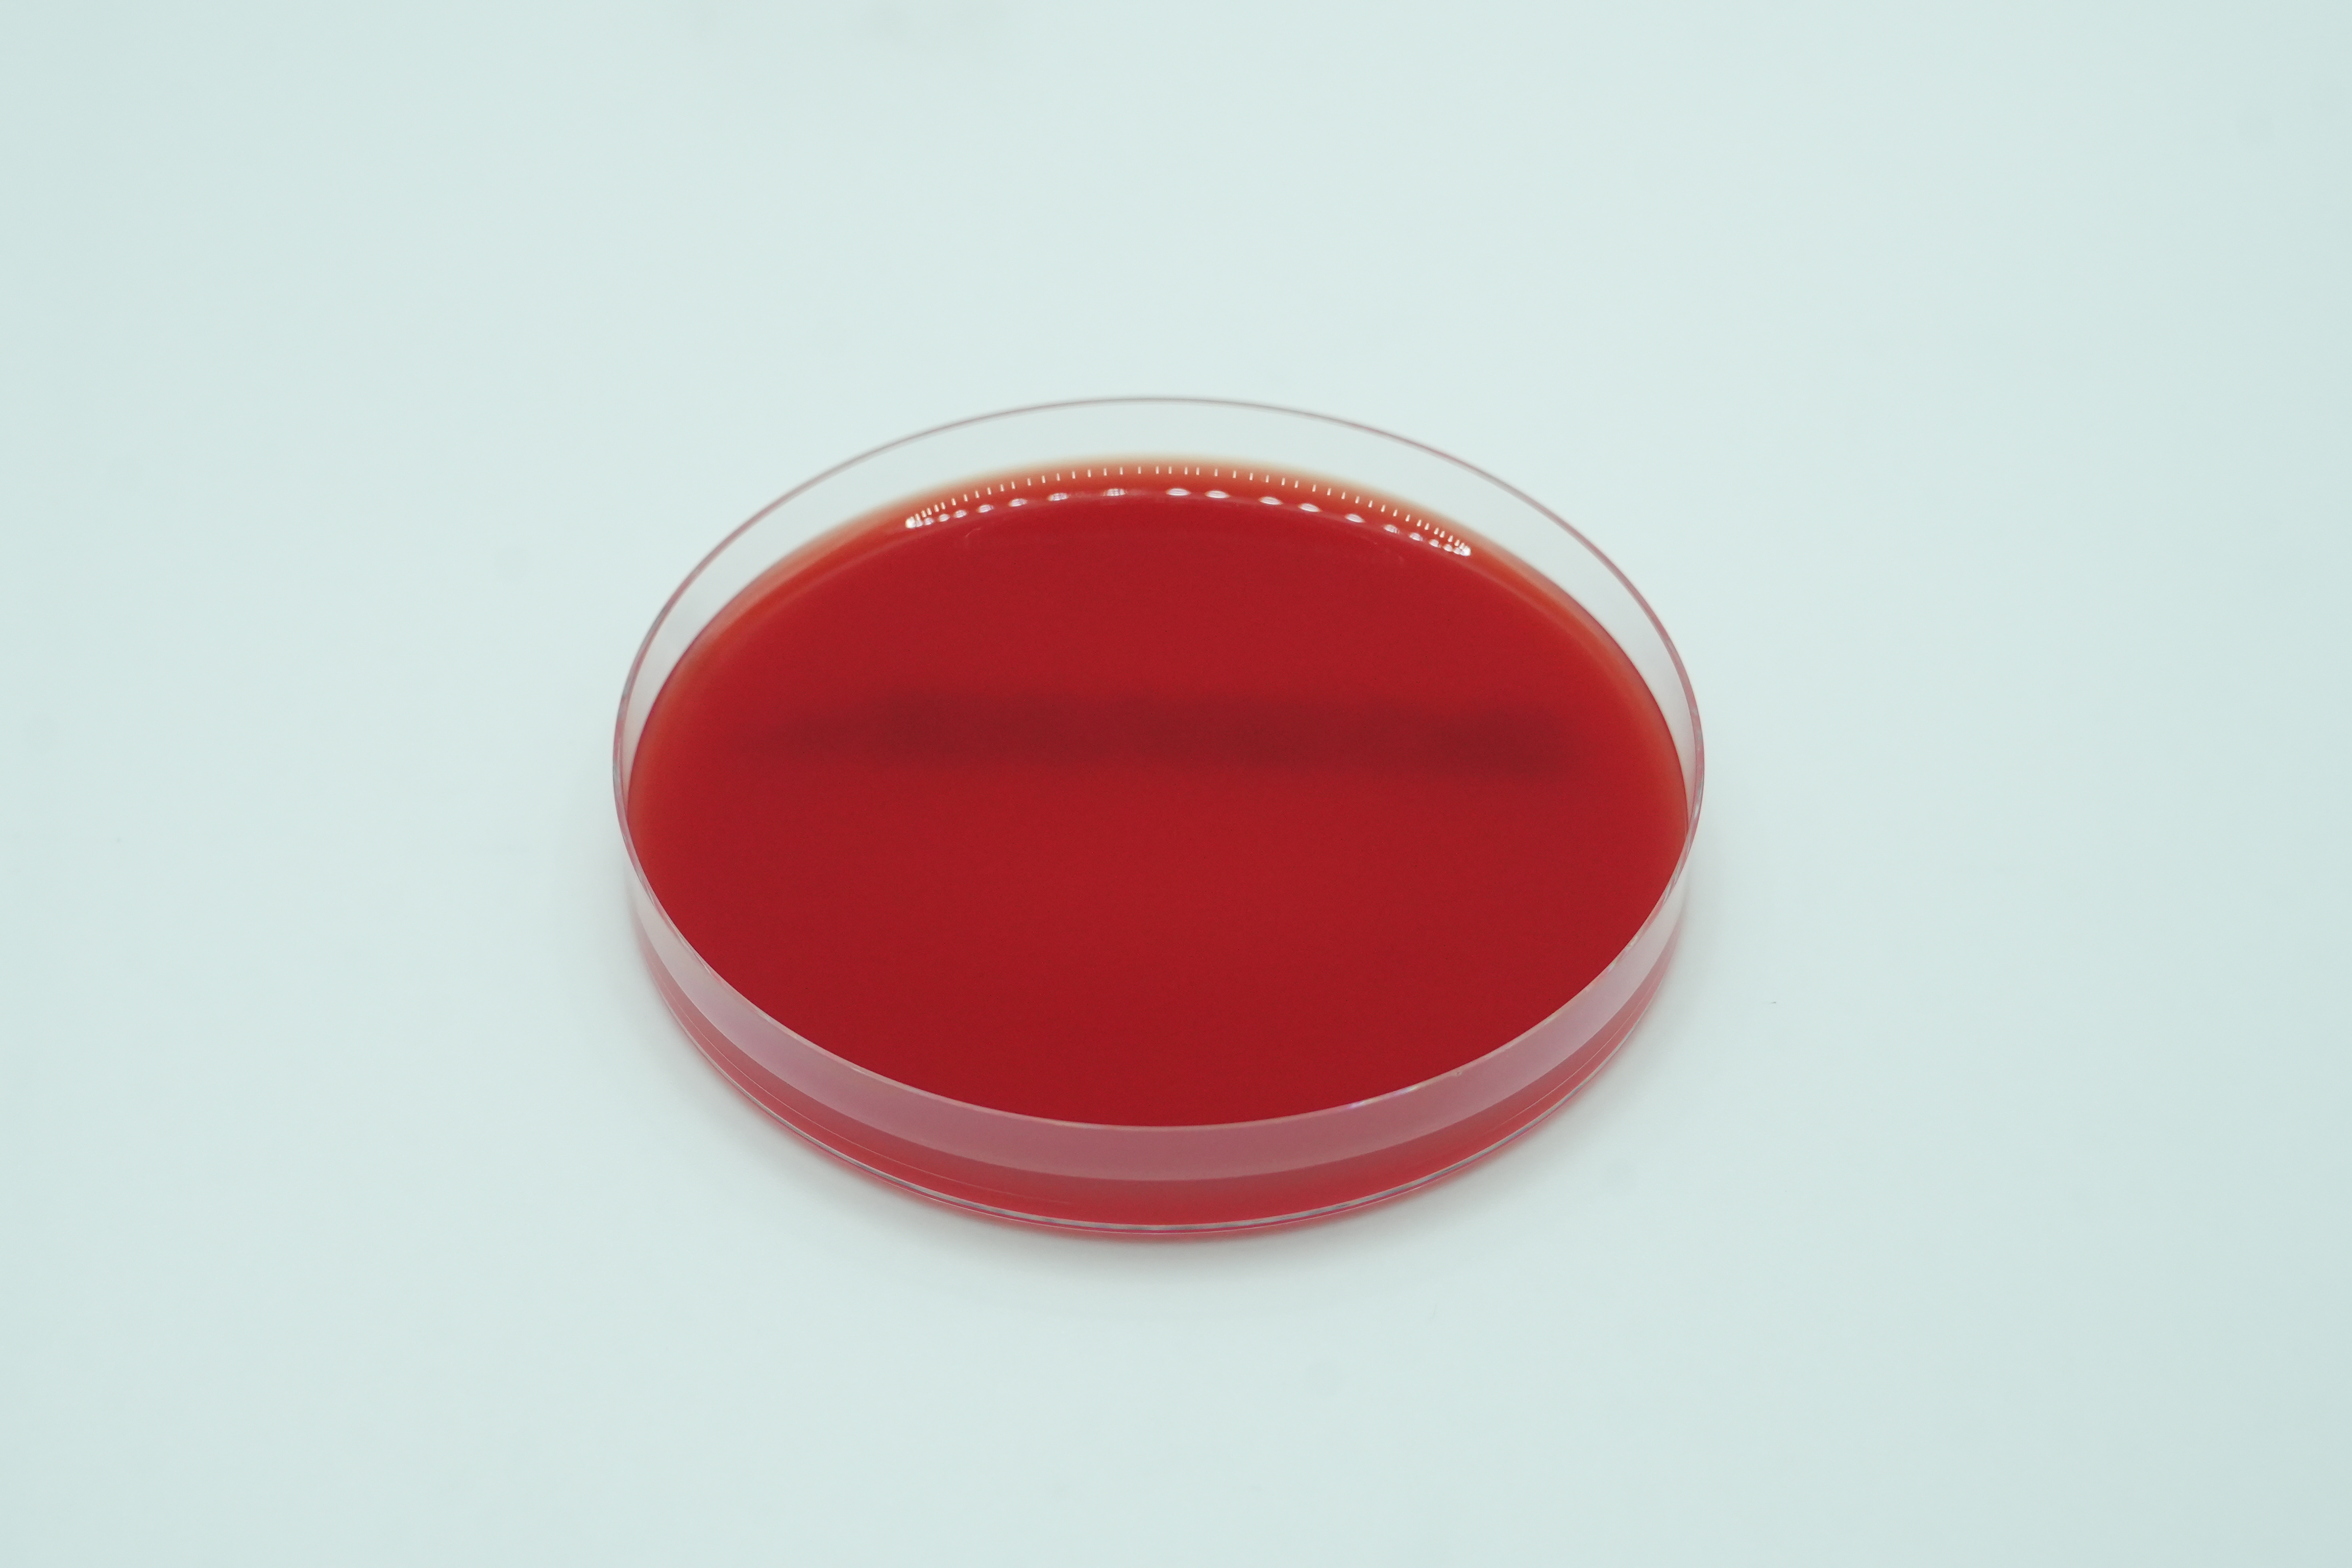

Thank you for your interest We will reach out to you

Oops! Something went wrong while submitting the form.
.svg)
Find a Product
Thank you! Your submission has been received!
Oops! Something went wrong while submitting the form.

Brain Heart Infusion Broth With 6.5% Sodium Chloride
4321015

Legionella with MWY Agar
110809

Dermatophyte Agar
110405

Triple Sugar Iron Slant
4321038

MacConkey Agar With Sorbitol
111310

Selectrol® Proteus vulgaris NCTC® 4175 / ATCC® 13315

Yeast Extract Agar 90MM
110238

Selectrol® Clostridium sporogenes NCTC® 532 / ATCC® 19404

Trypticase Soy Agar with Lecithin and Polysorbate 80, Rodac Plates
112010

Sabouraud Dextrose Agar w Cycloheximide
111912

Selectrol® Enterococcus faecalis NCTC® 775 / ATCC® 19433

GBS Agar
110702

Diabetica Travel Bag
110203

Columbia CNA Blood Agar/MacConkey Agar Biplate
120413

Salmonella Shigella Agar
111902

Selectrol® Bacillus subtilis subsp spizizenii NCTC® 10400 / ATCC® 6633

Selectrol® Yersinia enterocolitica NCTC® 12982 / ATCC® 9610

Selectrol® Escherichia coli (mcr-1) NCTC® 13846

Selectrol® Bacillus cereus NCTC® 7464 / ATCC® 10876

Campy 5 Blood Agar
110301

Selectrol® Klebsiella aerogenes NCTC® 10006 / ATCC® 13048

Trypticase Soy Agar w 2% NaCl
112005

Peptone Water 5ml
416001

Selectrol® Escherichia coli NCTC® 11560

Selectrol® Klebsiella pneumoniae (CRE) NCTC® 13440

Selectrol® Clostridium perfringens NCTC® 8237 / ATCC® 13124

Hoyle Agar
110805

Trypticase Soy with Lecithin and Polysorbate 80
112006

Sabouraud Dextrose Agar Rodac Plates
112012

Influenza A+B Rapid Test Kit
511501

Sheep Blood Agar/Sheep Blood Agar Biplate
120411

Selectrol® Klebsiella pneumoniae (CRE) NCTC® 13438

Cooked Meat Broth
4321507

TSB w/ 15% Glycerol
4397809

Chocolate Agar 150
211303

Campylobactor BLD-Free Sel. Medium
110316

DNASE Test Agar
110402

Gram's safranin O
1004

Bile Esculin Agar Slants
4321813

Selectrol® Listeria monocytogenes NCTC® 11994

Methicillin Resistant S. aureus (MRSA) Agar
111308

Oxytetracycline Glucose Yeast Agar 90MM
110237

MRS Agar 90MM
110235

Selectrol® Escherichia coli NCTC® 11954 / ATCC® 35218

Mueller Hinton Horse Blood Agar
111311

Selectrol® Saccharomyces cerevisiae NCTC® 10716 / ATCC® 9763

Selectrol® Salmonella Typhimurium NCTC® 12023/ ATCC® 14028

Blood/MacConkey Agar Biplate
120401
%201.png)
Mueller Hinton Broth (5 ml)
4397220

Selectrol® Rhodococcus hoagii NCTC® 1621 / ATCC® 6939

Selectrol® Salmonella Nottingham NCTC® 7832

BHI Agar w Vancomycin
110214

Selectrol® Neisseria gonorrhoeae NCTC® 12700 / ATCC® 49226

Selectrol® Streptococcus agalactiae NCTC® 8181 / ATCC® 13813

Selectrol® Klebsiella pneumoniae (CRE) NCTC® 13442

Selectrol® Salmonella Typhimurium NCTC® 12023/ ATCC® 14028

Rappaport Broth
418001

Cled Agar
110305

MEDYFAST-RT RSV Kit 20 tests
511502
%201.png)
Sabouraud Dextrose Agar (Deep filled)
111901

SABHI Agar
111913

Pseudomonas Isolation Agar
111604

Legionella GVPC Selective Agar 60MM
113004

Enterococcus Agar 90MM
110233

CHROMagar Y.enterocolitica
110332

Legionella GVPC Selective Agar 60MM
113004

Sab Dex w Gentamicin& Chloramphenicol
111910

Violet Red Bile Glucose (VRBG) Agar
112201

Selectrol® Staphylococcus aureus NCTC® 7447 / ATCC® 6538P

Selectrol® Klebsiella pneumoniae (CRE) NCTC® 13443

Thiosul. Citrate Bile Salts Sucr. (TCBS) Agar
112001

Selectrol® Aspergillus brasiliensis NCPF® 2275 / ATCC® 16404

Carbolfuchsin Stain-ZN Acid Fast Stain
1008

Nutrient Agar Slants 4
21001

Salt Broth 6.5%
419001

Desoxycholate Citr. Lact. Sucr. (DCLS) Agar
110403

Helicobacter Pylori Sel Medium
110806

Selectrol® Staphylococcus aureus NCTC® 12973 / ATCC® 29213

Selectrol® Bacillus cereus NCTC® 10320 / ATCC® 9634

Selectrol® Escherichia coli (CRE) NCTC® 13476

Trypticase Soy Blood Agar
112004

CHROMagar Acinetobacter w/MDR
110324

SABHI Agar with Cycloheximide and Chloramphenicol Slants
4321019

Selectrol® Klebsiella pneumoniae NCTC® 13368 / ATCC® 700603

Chrom Candida PLUS
110340

Medysinal Urecare Cream
110108

Selectrol® Lactobacillus brevis NCTC® 13386 / ATCC® 8287

Selectrol® Listeria monocytogenes NCTC® 13372 ATCC® 7644

MacConkey Agar CS
111313
DRBC (Dichloran Rose-Bengal Chloramphenicol) Agar 90MM
110229

Pseudosel Agar(Cetrimide)
111603

CDC Anaerobic Blood Agar
110302

Selectrol® Candida albicans NCPF® 3255 / ATCC® 2091

Mueller Hinton Agar
111305
Mueller Hinton Blood Agar 150
111306

Medygraine 50Mg
110102

Selectrol® Pseudomonas aeruginosa NCTC® 13359 / ATCC® 15442

Diabetica Wallet Organizer
110204

Mannitol Selenite F-Broth
4321022

MR-VP Test Medium
4321667
.svg)

.svg)
.svg)